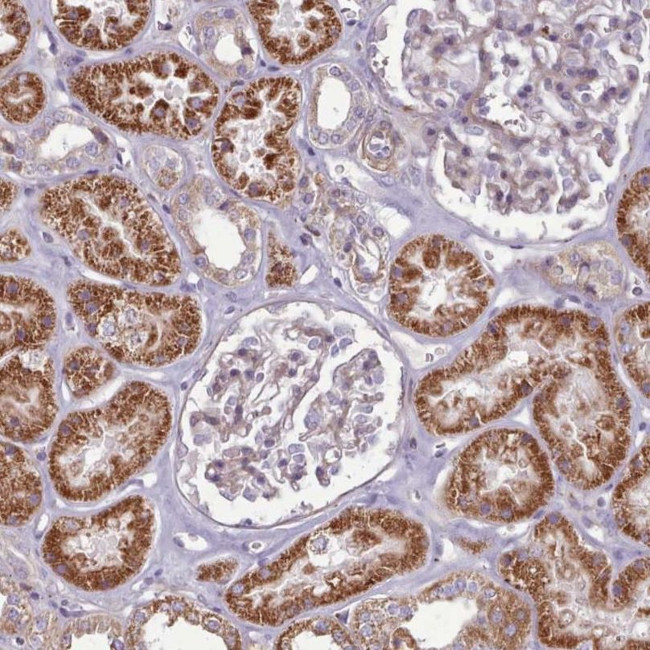
PAPD5 Antibody in Immunohistochemistry (IHC)

Search
Invitrogen
PAPD5 Polyclonal Antibody
{{$productOrderCtrl.translations['antibody.pdp.commerceCard.promotion.promotions']}}
{{$productOrderCtrl.translations['antibody.pdp.commerceCard.promotion.viewpromo']}}
{{$productOrderCtrl.translations['antibody.pdp.commerceCard.promotion.promocode']}}: {{promo.promoCode}} {{promo.promoTitle}} {{promo.promoDescription}}. {{$productOrderCtrl.translations['antibody.pdp.commerceCard.promotion.learnmore']}}
产品信息
PA5-61689
种属反应
宿主/亚型
分类
类型
抗原
偶联物
形式
浓度
规格
纯化类型
保存液
内含物
保存条件
运输条件
RRID
产品详细信息
Immunogen sequence: YYPNNETESI LGRIIRVTDE VATYRDWISK QWGLKNRPEP SCNGNGVTLI VDTQQLDKCN NNLSEENEAL GKCRSKTSES LSKHSSNSSS GPVS
Highest antigen sequence identity to the following orthologs: Mouse - 95%, Rat - 94%.
靶标信息
Terminal nucleotidyltransferase that catalyzes preferentially the transfert of ATP and GTP on RNA 3' poly(A) tail creating a heterogeneous 3' poly(A) tail leading to mRNAs stabilization by protecting mRNAs from active deadenylation (PubMed:21788334, PubMed:30026317). Also functions as a catalytic subunit of a TRAMP-like complex which has a poly(A) RNA polymerase activity and is involved in a post-transcriptional quality control mechanism. Polyadenylation with short oligo(A) tails is required for the degradative activity of the exosome on several of its nuclear RNA substrates. Doesn't need a cofactor for polyadenylation activity (in vitro) (PubMed:21788334, PubMed:21855801). Required for cytoplasmic polyadenylation of mRNAs involved in carbohydrate metabolism, including the glucose transporter SLC2A1/GLUT1 (PubMed:28383716). Plays a role in replication-dependent histone mRNA degradation, probably through terminal uridylation of mature histone mRNAs. May play a role in sister chromatid cohesion (PubMed:18172165). Mediates 3' adenylation of the microRNA MIR21 followed by its 3'-to-5' trimming by the exoribonuclease PARN leading to degradation (PubMed:25049417). Mediates 3' adenylation of H/ACA box snoRNAs (small nucleolar RNAs) followed by its 3'-to-5' trimming by the exoribonuclease PARN which enhances snoRNA stability and maturation (PubMed:22442037). [UniProt]
仅用于科研。不用于诊断过程。未经明确授权不得转售。
篇参考文献 (0)
生物信息学
蛋白别名: Non-canonical poly(A) RNA polymerase PAPD5; PAP associated domain containing 5; PAP-associated domain-containing protein 5; poly(A) RNA polymerase D5, non-canonical; Terminal guanylyltransferase; terminal nucleotidyltransferase 4A; Terminal nucleotidyltransferase 4B; Terminal uridylyltransferase 3; Topoisomerase-related function protein 4-2; TRF4-2; Trf4-2p; TUTase 3; unnamed protein product
基因别名: GLD4; PAPD5; TENT4B; TRF4-2; TUT3
UniProt ID: (Human) Q8NDF8
Entrez Gene ID: (Human) 64282